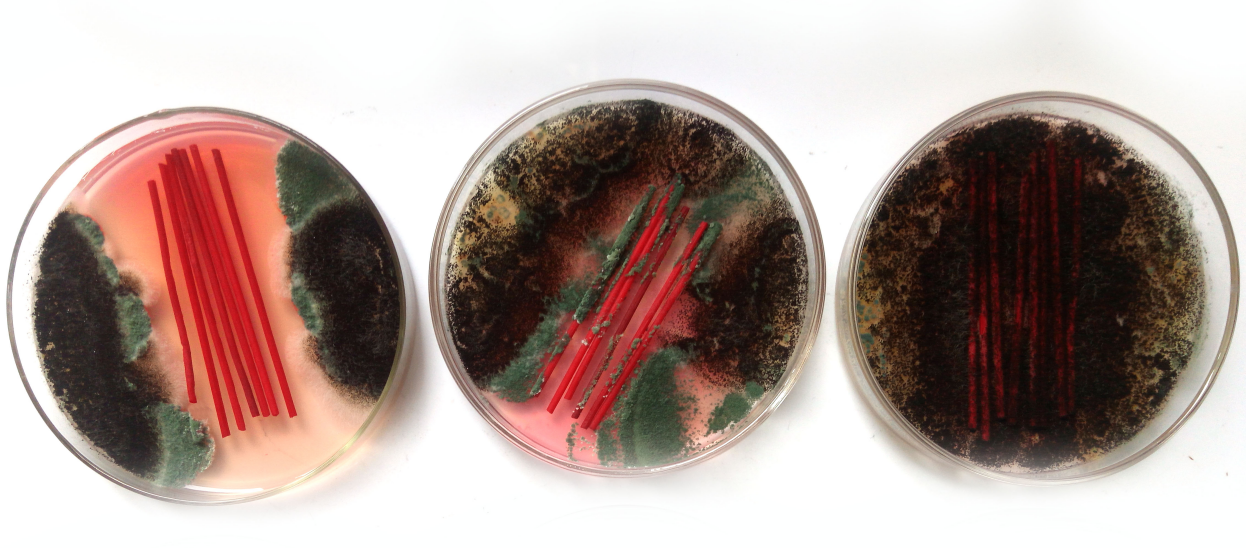
0023331.png

佛香防霉靈1號Micro-KS174是集多種防霉劑、抗菌劑、抗藻劑復合而成,主要針對竹簽這類細小竹材及竹制品使用。本產品對竹纖維具有天然的親和力,能夠在竹纖維表面固化成膜,與纖維結合成非常均勻致密的藥劑保護層,并且不會影響竹簽本身的顏色。多組分復合乳化而成的防霉劑,對佛香感染霉菌有特效,能夠防止所有佛香易滋生的霉菌,對佛香做全面保護。
合作客戶使用防霉靈1號后,均能達到防霉效果,佛香在存放、運輸等環(huán)節(jié)均不再長霉。

產品名稱 | 佛香防霉靈1號 | 產品型號 | Micro-KS174 | 密 度 | 1.02g/ml |
主要成分 | IPBC、四代季銨鹽、OIT | ||||
PH | 6-7.0 | 外觀 | 微黃透明液體 | 可燃性 | 不可燃 |
自燃溫度 | 無 | 分解溫度 | 260℃ | 爆炸危險 | 不產生爆炸 |
溶解度 | 溶于水、溶于乙醇 | ||||
禁配物 | 強酸、強堿、陰離子化合物 | ||||
抑制微生物的最小濃度(MIC)
微生物 | MIC(mg/kg) | 微生物 | MIC(mg/kg) | 微生物 | MIC(mg/kg) |
黑曲霉 | 25 | 黃曲霉 | 26 | 大腸桿菌 | 45 |
宛氏擬青霉 | 28 | 球毛殼霉 | 30 | 金黃色葡萄球菌 | 40 |
蠟葉芽枝霉 | 30 | 變色曲霉 | 20 | 白色念球菌 | 38 |
綠粘帚霉 | 30 | 枝孢芽枝菌 | 43 | 釀酒酵母 | 32 |
繩狀青霉 | 32 | 短柄帚霉 | 35 | 短乳桿菌 | 42 |
橘色藻 | 35 | 普通小球藻 | 40 | 巔藻 | 50 |
枯草桿菌 | 40 | 絲藻 | 42 | 巨大芽孢桿菌 | 55 |
特別說明 | 本抗菌防藻劑主要針對霉菌、藻類,常見細菌,適用環(huán)境PH5-10 | ||||

1、廣譜防霉抗菌性:具有非常廣泛的抗菌譜,對霉菌和藻類、常見細菌都具明顯抑制效果(見MIC參數表);
2、防霉能力優(yōu)異:浸泡佛香防霉靈1號的竹簽,具有很好的防霉能力,防霉等級0級,抗藻等級為0級,常見細菌抗菌率大于99%;
3、與水、溶劑均不相容,不會游離,遷移、流失??杀Wo制品3年以上不受霉菌、藻類物質侵擾,延長使用壽命;
4、安全環(huán)保,添加量少,不會對人體和環(huán)境造成危害;
5、不影響其產品的任何化學、物理性質,不影響佛香粉在竹簽上的附著力;
6、所使用抗菌劑通過Reach、Rohs、DMF FREE、CP65等相關環(huán)保認證。

1、本產品在佛香中應用,將藥劑按照1:50比例稀釋,攪拌均勻,備用。

2、使用的時候需使用自來水,河水及湖水內含有大量微生物,對藥劑可能會造成部分消耗。
3、佛香防霉靈1號配合佛香防霉靈2號使用,防護更加徹底,更加全面。

應用領域 | 應用產品 |
竹簽制品 | 佛香、燒烤簽、仿花、仿草等 |

包裝:25KG 白色塑料桶。
儲存:化學性質穩(wěn)定、非危險品,密封存放于室內陰涼、通風、干燥處。未使用完的藥劑蓋好蓋子密封保存。儲存溫度:-20℃-60℃之間可保存24個月,生產日期見標簽上的生產批號。
儲存環(huán)境濕度: 40%-75%。擺放高度低于3層,避免陽光直曬。強酸、強堿化工原料擺放距離大于5米。
運輸:運輸中要密封好,防潮、防強堿強酸及防雨水等雜質混入。
我們能為客戶帶來什么?
為客戶提供安全保障
銘鎧與客戶一起,從原料、生產、成品等多個環(huán)節(jié)中,在關鍵節(jié)點設立管控程序,幫助客戶從源頭解決發(fā)霉問題。將客戶的產品的發(fā)霉率控制在千分之五以下,讓產品安全到達客戶手中,避免消投訴,降低罰款及信譽損失的風險。
為產品提升創(chuàng)新價值
隨著人們生活水平提高,市場同質化產品越來越明顯,銘鎧主張開放、合作、共贏,與客戶合作創(chuàng)新,創(chuàng)造差異化產品。銘鎧憑借多年的經驗和穩(wěn)定的產品在服裝、家具、電器、醫(yī)療、化工等行業(yè)為客戶開發(fā)了防霉、抗菌除臭等功能性產品,不僅提升了產品價值,同時還提升了產品的市場競爭力,上市的防霉抗菌制品更是得到廣大消費者的好評。
提升客戶核心競爭力
近幾年,客戶訂單減少,品質要求提高,制造成本增加,給國內很多生產企業(yè)帶來困擾。品牌商都逐步將防霉抗菌納入品質管控程序,防霉抗菌應對方法也逐步成為供應商考核指標之一。銘鎧專業(yè)技術團隊與客戶共進退,從產品設計、研發(fā)、制造、交付以及運輸環(huán)節(jié),為客戶提供領先的防霉抗菌產品和解決方案,讓企業(yè)在產品有效性與穩(wěn)定性上更具有競爭力,成功拿到客人訂單,按時按質交出滿意產品。














